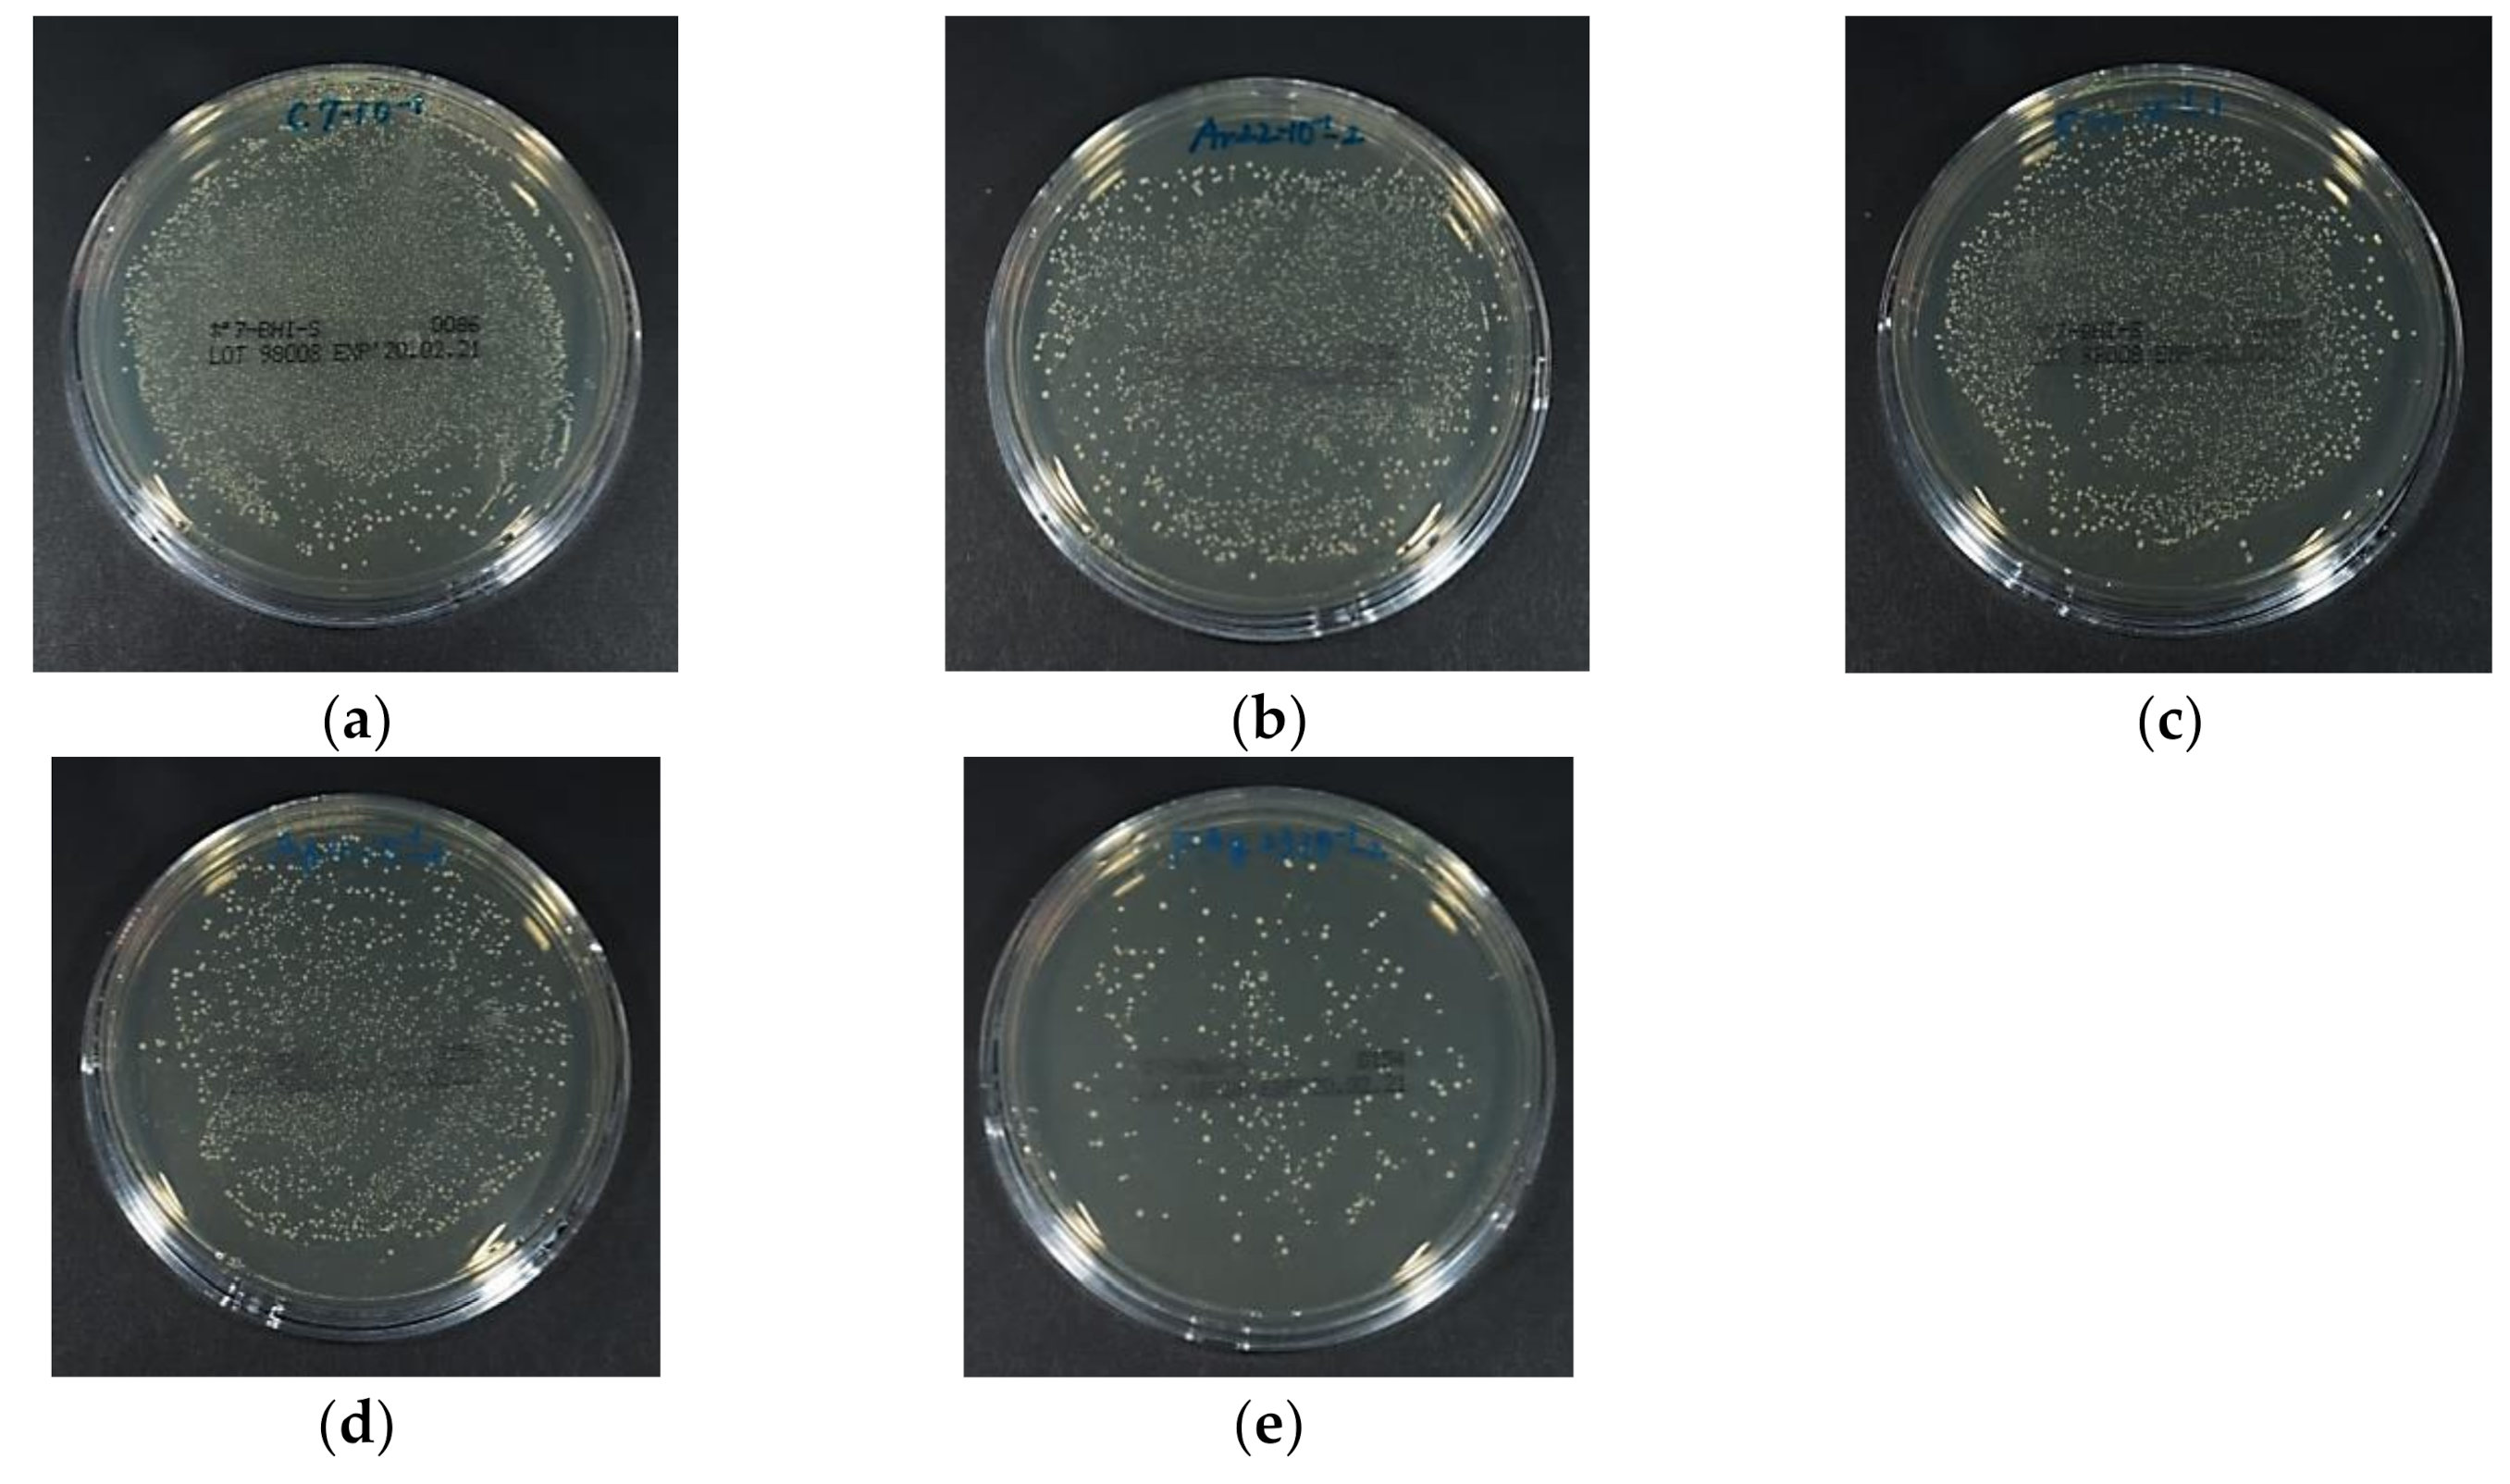
Materials 13 04525 g007 Materials 13 04525 g007
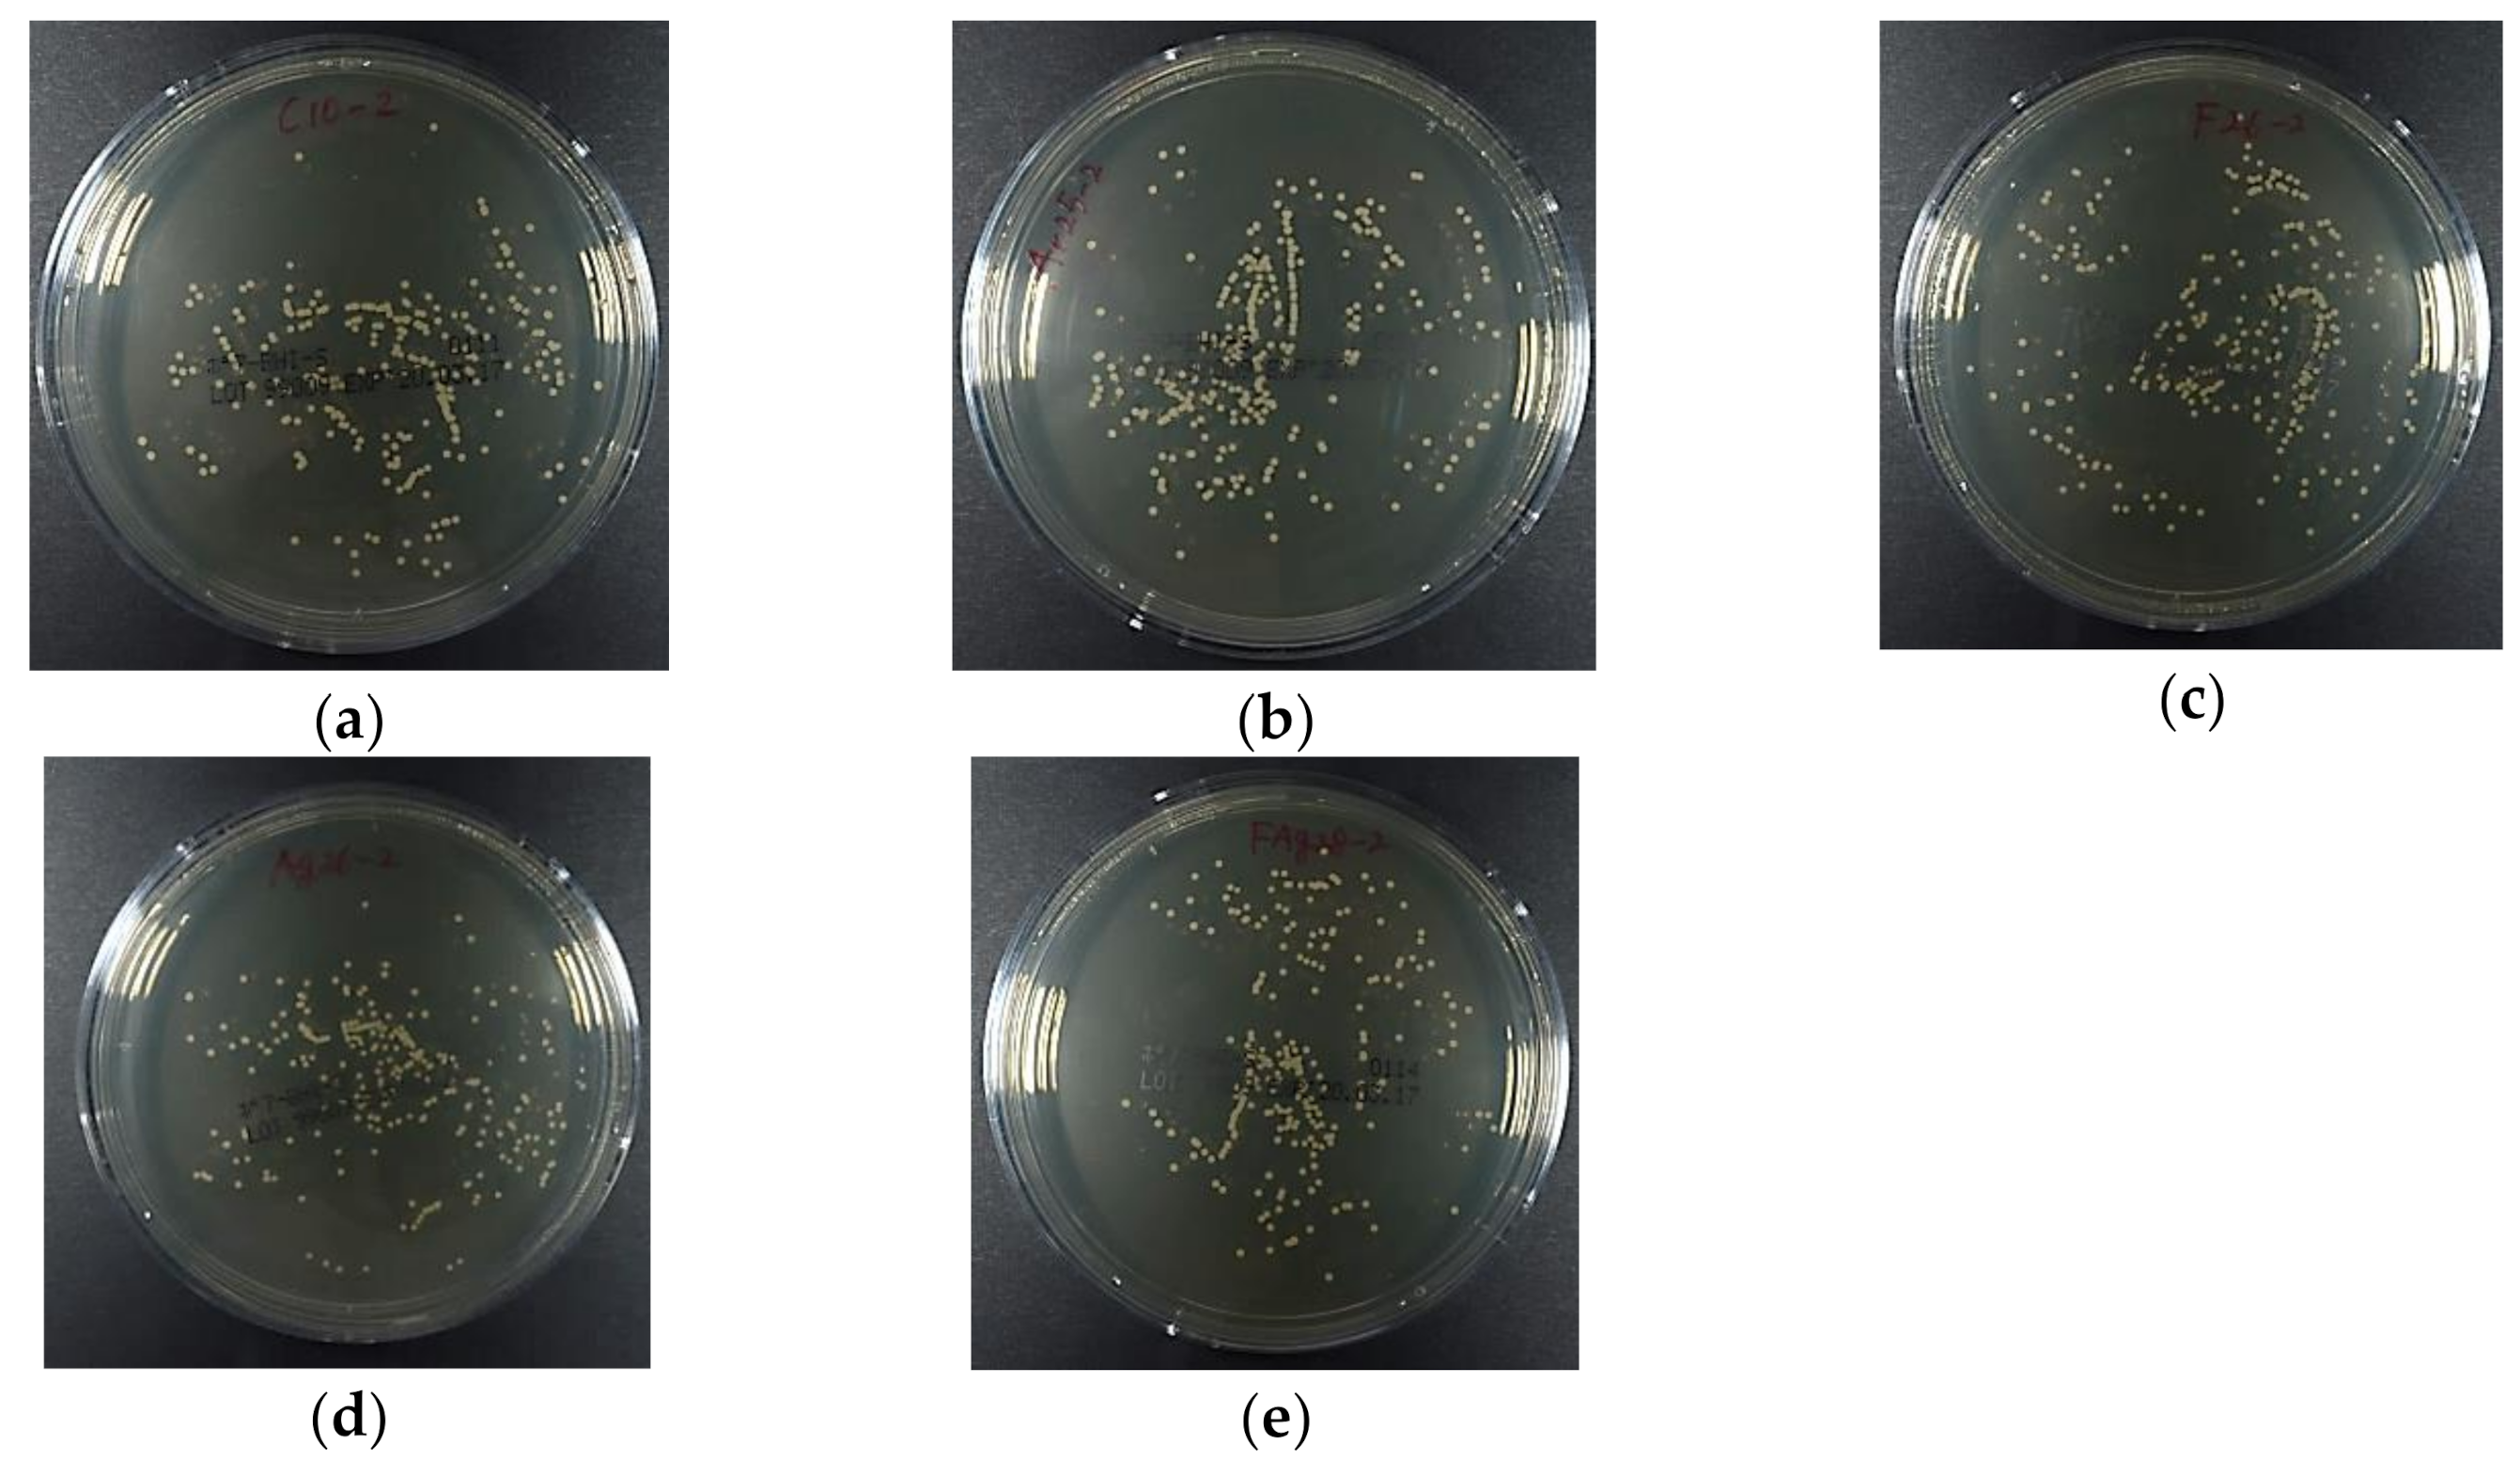
Materials 13 04525 g009 Materials 13 04525 g009

Antibacterial and Antifungal Activities of PMMAs Implanted Fluorine and/or Silver Ions by Plasma-Based Ion Implantation with Argon
Abstract
1. Introduction
2. Materials and Methods
2.1. Materials
2.2. Elemental Analysis
2.3. Contact Angle Measurement
2.4. Atomic Force Microscopic Analysis
2.5. Antimicrobial Test
2.6. Statistical Analysis
3. Results
3.1. XPS Analysis
3.2. Contact Angle and Surface Energy Analysis
3.3. AFM Analysis
3.4. Antibacterial Activity Against S. Mutans
3.5. Antifungal Activity Against C. Albicans
4. Discussion
5. Conclusions
Author Contributions
Funding
Acknowledgments
Conflicts of Interest
References
- Fang, J.; Wang, C.; Li, Y.; Zhao, Z.; Mei, L. Comparison of bacterial adhesion to dental materials of polyethylene terephthalate (PET) and polymethyl methacrylate (PMMA) using atomic force microscopy and scanning electron microscopy. Scanning 2016, 38, 665–670. [Google Scholar] [CrossRef] [PubMed]
- Zafar, M.S.; Ahmed, N. Nanoindentation and surface roughness profilometry of poly methyl methacrylate denture base materials. Technol. Health Care 2014, 22, 573–581. [Google Scholar] [CrossRef] [PubMed]
- Schubert, A.; Wassmann, T.; Holtappels, M.; Kurbad, O.; Krohn, S.; Bürgers, R. Predictability of microbial adhesion to dental materials by roughness parameters. Coatings 2019, 9, 456. [Google Scholar] [CrossRef]
- Nikawa, H.; Hamad, T.; Yamamoto, T. Denture plaque—Past and recent concerns. J. Dent. 1998, 26, 299–304. [Google Scholar] [CrossRef]
- Bjerklin, K.; Gärskog, B.; Rönnerman, A. Proximal caries increment in connection with orthodontic treatment with removable appliances. Br. J. Orthod. 1983, 10, 21–24. [Google Scholar] [CrossRef]
- Kulak, Y.; Arikan, A.; Albak, S.; Okar, I.; Kazazoğlu, E. Scanning electron microscopic examination of different cleaners: Surface contaminant removal from dentures. J. Oral. Rehabil. 1997, 24, 209–215. [Google Scholar] [CrossRef]
- Takeuchi, K.; Izumi, M.; Furuta, M.; Takeshita, T.; Shibata, Y.; Kageyama, S.; Ganaha, S.; Yamashita, Y. Posterior teeth occlusion associated with cognitive function in nursing home older residents: A cross-sectional observational study. Plos One 2015, 10, e0141737. [Google Scholar] [CrossRef]
- Takeuchi, K.; Izumi, M.; Furuta, M.; Takeshita, T.; Shibata, Y.; Kageyama, S.; Okabe, Y.; Akifusa, S.; Ganaha, S.; Yamashita, Y. Denture wearing moderates the association between aspiration risk and incident pneumonia in older nursing home residents: A prospective cohort study. Int. J. Environ. Res. Public Health 2019, 16, 554. [Google Scholar] [CrossRef]
- Sumi, Y.; Miura, H.; Sunakawa, M.; Michiwaki, Y.; Sakagami, N. Colonization of denture plaque by respiratory pathogens in dependent elderly. Gerodontlogy 2002, 19, 25–29. [Google Scholar] [CrossRef]
- Scannapieco, F.A. Pneumonia in nonambulatory patients—the role of oral bacteria and oral hygiene. J. Am. Dent. Assoc. 2006, 137, 21s–25s. [Google Scholar] [CrossRef]
- Nakanoda, N.; Nikawa, H.; Hamada, T.; Yamamoto, T.; Nakamoto, K. The material and antifungal properties of antibiotic Zeolite incorporated acrylic resin. J. Jpn. Prosthodont. Soc. 1995, 39, 919–926. [Google Scholar] [CrossRef]
- Sakoh, M. Study on denture base resin containing of antibacterial agents: Mechanical properties and antibacterial activities. J. Jpn. Prosthodont. Soc. 2000, 44, 226–233. [Google Scholar] [CrossRef]
- Conrad, J.R.; Radtke, J.L.; Dodd, R.A.; Worzala, F.J.; Tran, N.C. Plasma source ion-implantation technique for surface modification of materials. J. Appl. Phys. 1987, 62, 4591–4596. [Google Scholar] [CrossRef]
- Arita, K.; Shinonaga, Y.; Nishino, M. Plasma-based fluorine ion implantation into dental materials for inhibition of bacterial adhesion. Dent. Mater. J. 2006, 25, 684–692. [Google Scholar] [CrossRef] [PubMed]
- Shinonaga, Y.; Arita, K. Surface modification of stainless steel by plasma-based fluoride and silver dual ion implantation and deposition. Dent. Mater. J. 2009, 28, 735–742. [Google Scholar] [CrossRef] [PubMed]
- Shinonaga, Y.; Arita, K. Antibacterial effect of acrylic dental devices after surface modification by fluorine and silver dual-ion implantation. Acta Biomater. 2012, 8, 1388–1393. [Google Scholar] [CrossRef]
- Dewhirst, F.E.; Chen, T.; Izard, J.; Paster, B.J.; Tanner, A.C.R.; Yu, W.H.; Laskshmanan, A.; Wade, W.G. The human oral microbiome. J. Bacteriol. 2010, 192, 5002–5017. [Google Scholar] [CrossRef]
- Metwalli, K.H.; Khan, S.A.; Krom, B.P.; Jabra-Rizk, M.A. Streptococcus mutans, Candida albicans, and the human mouth: A sticky situation. Plos Pathog. 2013, 9, e1003616. [Google Scholar] [CrossRef]
- Crispian, S. Denture-related stomatitis. In Oral and Maxillofacial Medicine: The Basis of Diagnosis and Treatment, 3rd ed.; Churchill Livingstone: Edinburgh, UK, 2013; pp. 264–267. [Google Scholar]
- Liu, Y.; Zhao, Q. Influence of surface energy of modified surfaces on bacterial adhesion. Biophys. Chem. 2015, 117, 39–45. [Google Scholar] [CrossRef]
- Young, T., III. An essay on the cohesion of fluids. Philos. Trans. R Soc. 1805, 95, 65–87. [Google Scholar] [CrossRef]
- Van Oss, C.J.; Chaudhury, M.K.; Good, R.J. Interfacial Lifshltz-van der Waals and polar interactions in macroscopic systems. Chem. Rev. 1988, 88, 927–941. [Google Scholar] [CrossRef]
- Ministry of Environment, Japan, Greenhouse Gas Inventory Office of Japan, CGER, NIES. National Greenhouse Gas Inventory Report of Japan 2019. Available online: http://www-gio.nies.go.jp/aboutghg/nir/2019/NIR-JPN-2019-v3.0_GIOweb.pdf/ (accessed on 14 July 2020).
- Mühle, J.; Ganesan, A.L.; Miller, B.R.; Salameh, P.K.; Harth, C.M.; Greally, B.R.; Rigby, M.; Porter, L.W.; Steele, L.P.; Trudinger, C.M.; et al. Perfluorocarbons in the global atmosphere: Tetrafluoromethane, hexafluoroethane, and octafluoropropane. Atomos. Chem. Phys. 2010, 10, 5145–5164. [Google Scholar] [CrossRef]
- Oshida, Y.; Sellers, C.B.; Mirza, K.; Farzin-Nia, F. Corrosion of dental metallic by dental treatment agents. Mater. Sci. Eng. C 2005, 25, 343–348. [Google Scholar] [CrossRef]
- Ma, G.; Gong, S.; Zhang, L.; Lin, G.; Sun, G.; Wu, H. A study of enhancing hydrophobic property of the Ti alloy by PBII&D. Surf. Coat. Technol. 2013, 229, 31–35. [Google Scholar] [CrossRef]
- Tan, P.E.C.; Abalos, J.G.F.; Mahinay, C.L.S.; Culaba, I.B. Surface analysis and characterization of atmospheric pressure argon plasma jet treated methyl methacrylate monomer film. Jpn. J. Appl. Phys. 2020, 59, SAAB08. [Google Scholar] [CrossRef]
- Canullo, L.; Genova, T.; Wang, H.L.; Carossa, S.; Mussano, F. Plasma of argon increases cell attachment and bacterial decontamination on different implant surfaces. Int. J. Oral. Maxillofac. Implant. 2017, 32, 1315–1323. [Google Scholar] [CrossRef]
- Griffin, M.; Palgrave, R.; Baldovino-Medrano, V.G.; Butler, P.E.; Kalaskar, D.M. Argon plasma improves the tissue integration and angiogenesis of subcutaneous implants by modifing surface chemistry and topography. Int. J. Nanomed. 2018, 13, 6123–6141. [Google Scholar] [CrossRef]
- Yoda, I.; Koseki, H.; Tomita, M.; Shida, T.; Horiuchi, H.; Sakoda, H.; Osaki, M. Effect of surface roughness of biomaterials on staphylococcus epidermidis adhesion. Bmc Microbiol. 2014, 14, 234. [Google Scholar] [CrossRef]
- Bollen, C.M.; Lambrechts, P.; Quirynen, M. Comparison of surface roughness of oral hard materials to the threshold surface roughness for bacterial plaque retention: A review of the literature. Dent. Mater. 1997, 13, 258–269. [Google Scholar] [CrossRef]
- Lee, B.C.; Jung, G.Y.; Kim, D.J.; Han, J.S. Initial bacterial adhesion on resin, titanium and sirconia in vitro. J. Adv. Prosthodont 2011, 3, 81–84. [Google Scholar] [CrossRef]
- Davies, R.L.; Etris, S.F. The development and functions of silver in water purification and disease control. Catal. Today 1997, 36, 107–114. [Google Scholar] [CrossRef]
- Correa, J.M.; Mori, M.; Sanche, H.L.; Cruz, A.D.; Poiate, E.; Poiate, I.A.V.P. Silver nanoparticles in dental biomaterials. Int. J. Biomater. 2015, 2015, 4852. [Google Scholar] [CrossRef] [PubMed]
- Nam, K.Y. In vitro antimicrobial effect of the tissue conditioner containing silver nanoparticle. J. Adv. Prosthodont. 2011, 3, 20–24. [Google Scholar] [CrossRef] [PubMed]
- Lu, T.; Qu, Q.; Lavoie, M.; Pan, X.; Peijnenburg, W.J.G.M.; Zhou, Z.; Pan, X.; Cai, Z.; Qian, H. Insights into the transcriptional responses of a microbial community to silver nanoparticles in a freshwater microcosm. Environ. Pollut. 2020, 258, 10. [Google Scholar] [CrossRef] [PubMed]
- Panáček, A.; Kolář, M.; Večeřová, R.; Prucek, R.; Soukupová, J.; Kryštof, V.; Hamal, P.; Zbořil, R.; Kvítek, L. Antifungal activity of silver nanoparticles against Candida spp. Biomaterials 2009, 30, 333–6340. [Google Scholar] [CrossRef]
- Lou, Y.; Darvell, B.W.; Botelho, M. Antibacterial effect of silver diamine fluoride on cariogenic organisms. J. Contemp. Dent. Pract. 2018, 19, 591–598. [Google Scholar] [CrossRef]
- Teixeira, J.A.; Silva, A.V.C.; Santos, V.E., Jr.; Melo, J.P.C.; Arnaud, M.; Lima, M.G.; Flores, M.A.P.; Stamford, T.C.M.; Pereira, J.R.D.; Targino, A.G.R.; et al. Effects of a new nano-silver fluoride-containing dentifrice on demineralization on enamel and streptococcus mutans adhesion and acidogenicity. Int. J. Dent. 2018, 2018, 9. [Google Scholar] [CrossRef]
- Tsuji, H.; Satoh, H.; Ikeda, S.; Gotoh, Y.; Ishikawa, J. Contact angle lowering of polystyrene surface by silver-negative-ion implantation for improving biocompatibility and introduced atomic bond evaluation by XPS. Nucl. Instr. Meth. Phys. Res. B 1998, 141, 197–201. [Google Scholar] [CrossRef]
- Dalvi, V.H.; Rossky, P.J. Molecular origins of fluorocarbon hydrophobicity. PNAS 2010, 31, 13603–13607. [Google Scholar] [CrossRef]
- Brassard, J.D.; Sarkar, D.K.; Perron, J. Fluorine based superhydrophobic coating. Appl. Sci. 2012, 2, 453–464. [Google Scholar] [CrossRef]
- Tang, P.; Zhang, W.; Wang, Y.; Zhang, B.; Wang, H.; Lin, C.; Zhang, L. Effect of superhydrophobic surface of titanium on staphylococcus aureus adhesion. J. Nanomater. 2011. [Google Scholar] [CrossRef]

| Group | Gas | Ag Mesh |
|---|---|---|
| Control | - | - |
| Ar | 100% Ar | - |
| Ar/F | 95% Ar, 5% F2 | - |
| Ar+Ag | 100% Ar | + |
| Ar/F+Ag | 95% Ar, 5% F2 | + |
| Surface Tension Data (mJ/m2) | γL | γLLW | γLAB | γL+ | γL− |
|---|---|---|---|---|---|
| Water (W), H2O | 72.8 | 21.8 | 51.0 | 25.5 | 25.5 |
| Diiodomethane (D), CH2I2 | 50.8 | 50.8 | 0 | 0 | 0 |
| Ethylene Glycol (E), C2H6O2 | 48.0 | 29.0 | 19.0 | 1.92 | 47.0. |
| Group | Contact Angle θ (Degree) | Surface Energy Components (mJ/m2) | ||||||
|---|---|---|---|---|---|---|---|---|
| θW | θDi | θEG | γLW | γ+ | γ− | γAB | γTOT | |
| Control | 64.4 | 36.3 | 50.8 | 41.42 | 0.08 | 21.67 | 2.63 | 44.05 |
| Ar | 125.3 | 32.6 | 42.2 | 43.11 | 3.77 | 24.69 | 19.29 | 62.41 |
| Ar/F | 120.2 | 54.4 | 68.7 | 31.79 | 0.78 | 6.32 | 4.44 | 36.23 |
| Ar+Ag | 99.0 | 43.8 | 62.3 | 37.65 | 0.08 | 0.02 | 0.07 | 37.72 |
| Ar/F+Ag | 108.5 | 43.3 | 62.6 | 37.91 | 0.77 | 8.94 | 5.25 | 43.16 |
| Group | Mean ± S.D (nm) | Maximum (nm) | Minimum (nm) | |
|---|---|---|---|---|
| Control | 1.66 ± 1.17 | ![]() | 3.18 | 0.30 |
| Ar | 1.69 ± 0.19 | 1.92 | 1.49 | |
| Ar/F | 3.54 ± 1.78 | 5.64 | 1.61 | |
| Ar+Ag | 1.01 ± 0.04 | 1.04 | 0.95 | |
| Ar/F+Ag | 4.94 ± 0.60 | 5.65 | 4.23 | |
© 2020 by the authors. Licensee MDPI, Basel, Switzerland. This article is an open access article distributed under the terms and conditions of the Creative Commons Attribution (CC BY) license (http://creativecommons.org/licenses/by/4.0/).
Share and Cite
Kagami, K.; Abe, Y.; Shinonaga, Y.; Imataki, R.; Nishimura, T.; Harada, K.; Arita, K. Antibacterial and Antifungal Activities of PMMAs Implanted Fluorine and/or Silver Ions by Plasma-Based Ion Implantation with Argon. Materials 2020, 13, 4525. https://doi.org/10.3390/ma13204525
Kagami K, Abe Y, Shinonaga Y, Imataki R, Nishimura T, Harada K, Arita K. Antibacterial and Antifungal Activities of PMMAs Implanted Fluorine and/or Silver Ions by Plasma-Based Ion Implantation with Argon. Materials. 2020; 13(20):4525. https://doi.org/10.3390/ma13204525
Chicago/Turabian StyleKagami, Keiichi, Yoko Abe, Yukari Shinonaga, Rie Imataki, Takako Nishimura, Kyoko Harada, and Kenji Arita. 2020. "Antibacterial and Antifungal Activities of PMMAs Implanted Fluorine and/or Silver Ions by Plasma-Based Ion Implantation with Argon" Materials 13, no. 20: 4525. https://doi.org/10.3390/ma13204525
APA StyleKagami, K., Abe, Y., Shinonaga, Y., Imataki, R., Nishimura, T., Harada, K., & Arita, K. (2020). Antibacterial and Antifungal Activities of PMMAs Implanted Fluorine and/or Silver Ions by Plasma-Based Ion Implantation with Argon. Materials, 13(20), 4525. https://doi.org/10.3390/ma13204525

